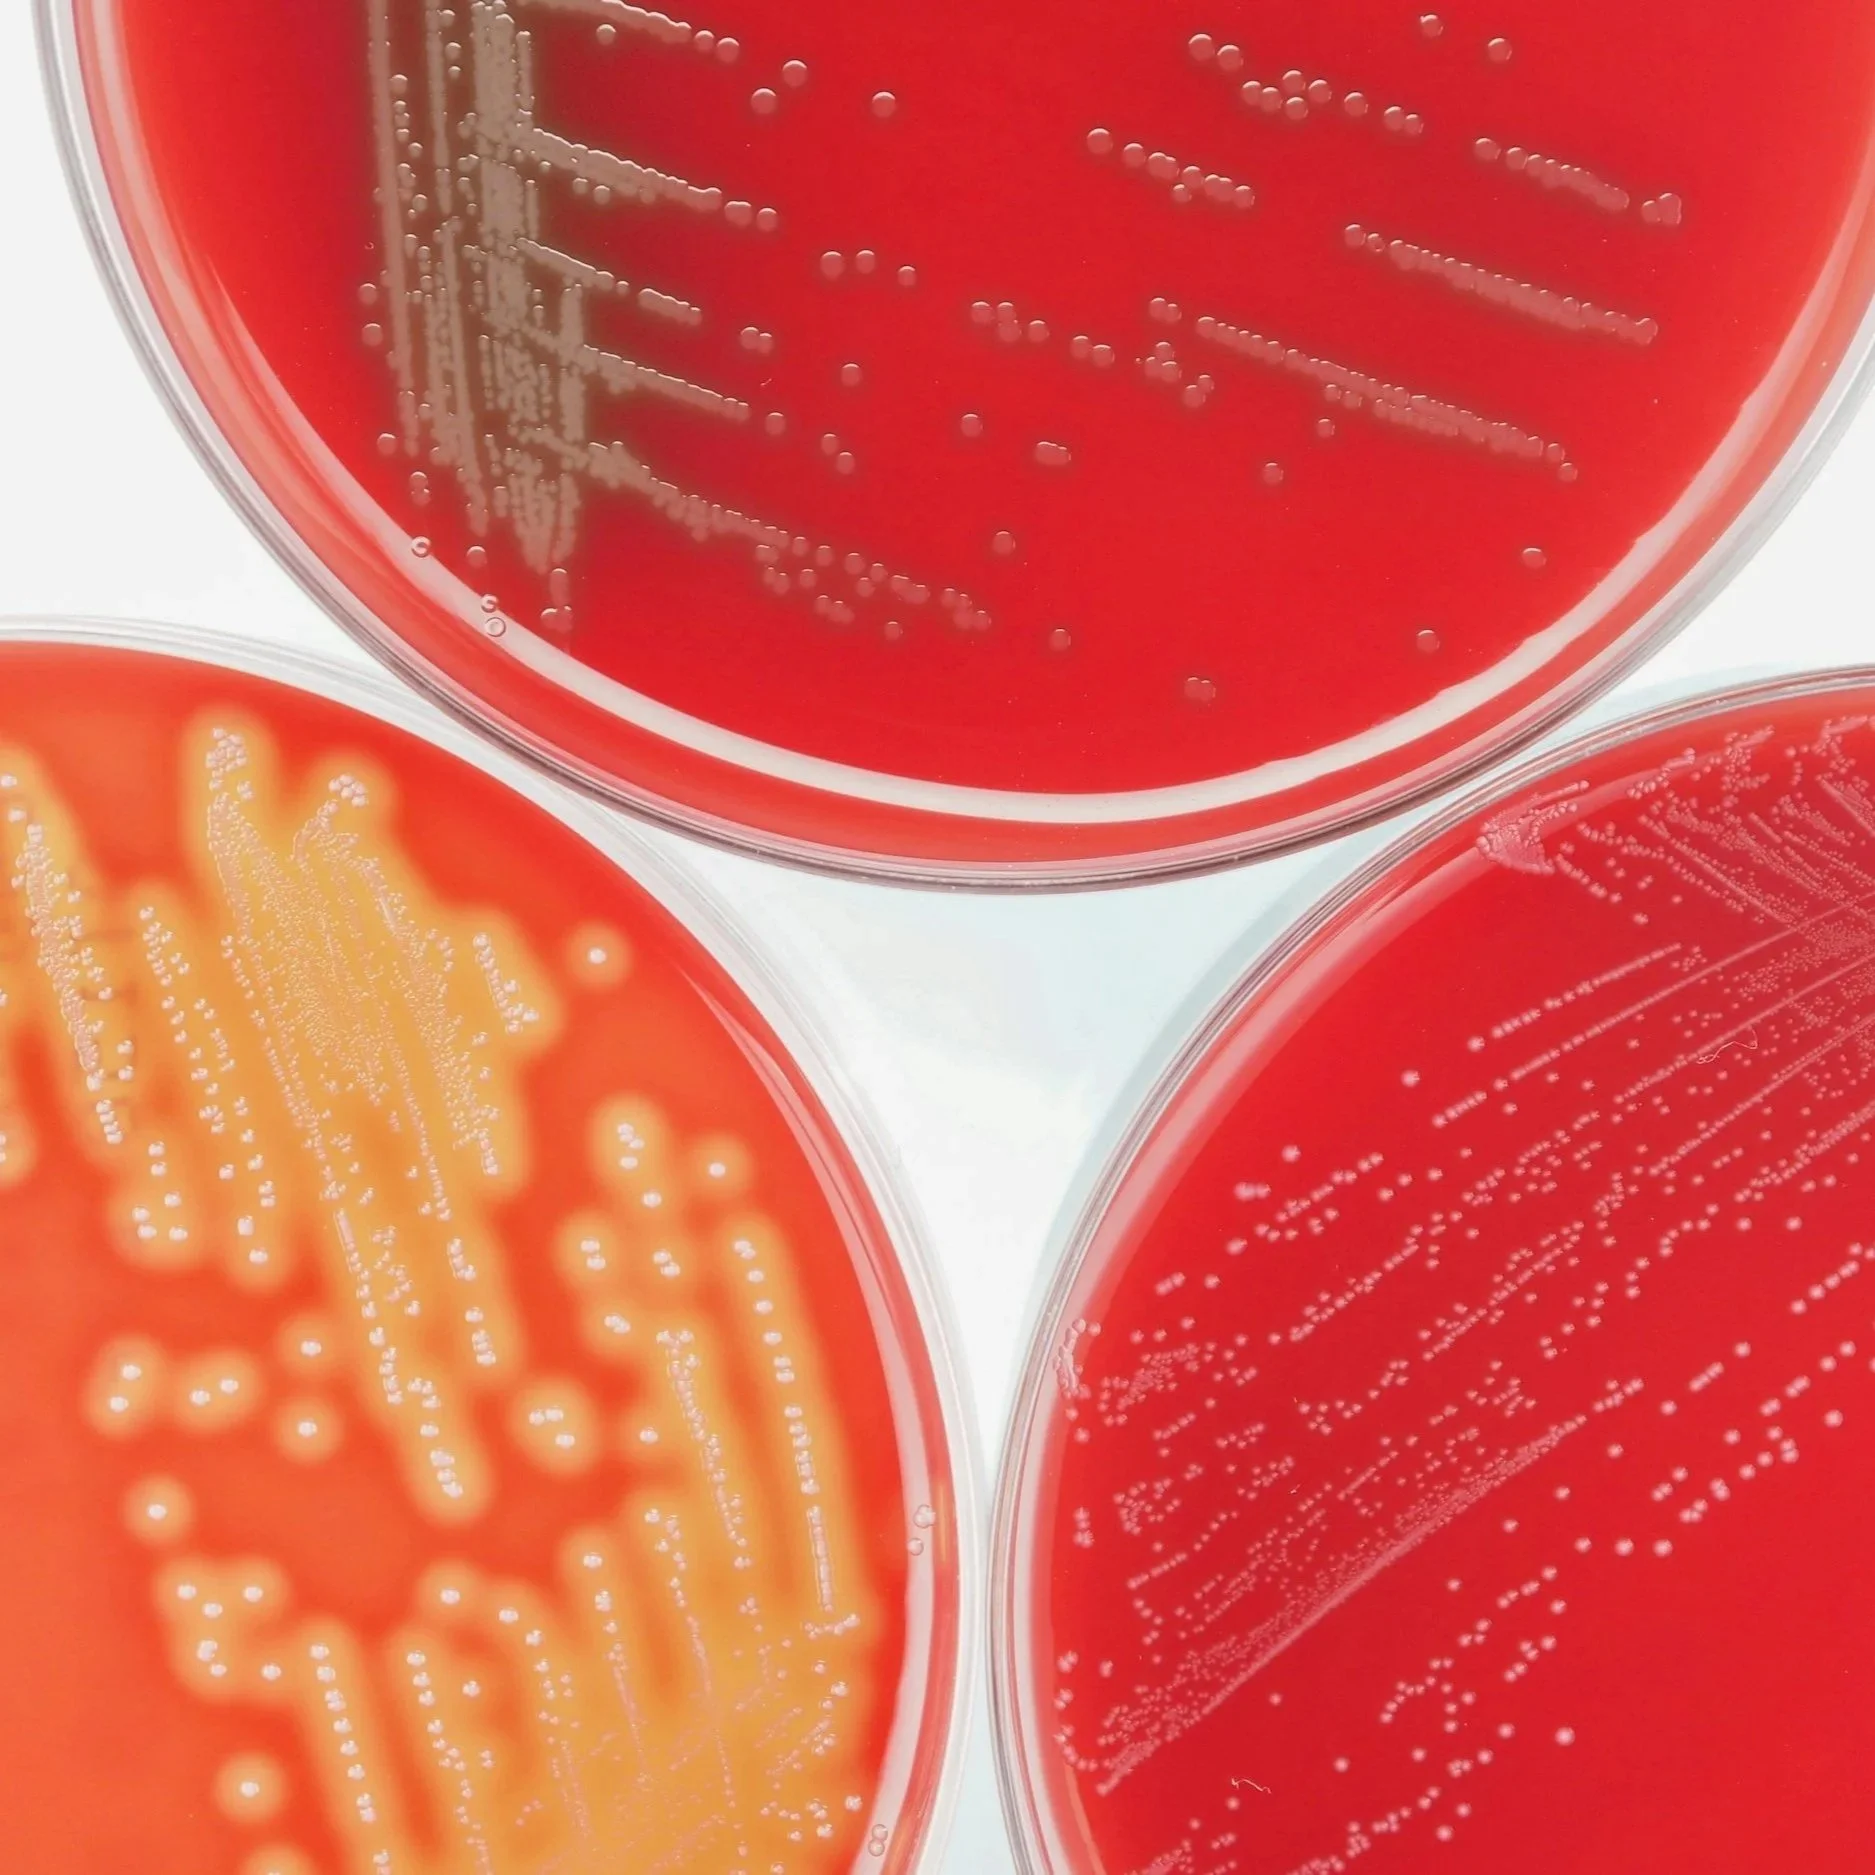
laboratory accreditation preparation and ISO 17025 readiness support

Strengthening Quality Systems to Secure Your Laboratory’s Accreditation
Who We Are
Led by Ashley Dennis, BS Chemistry
Analytical Chemist, Laboratory Accreditation Consultant, and Founder of LabAQP. Ashley specializes in laboratory quality systems and successfully led the transformation of the International Flavors & Fragrances Inc. (IFF) Clackamas laboratory into an accredited facility compliant with ISO/IEC 17025, GDP, and AOAC requirements.
Why LabAQP
✔ Led successful ISO/IEC 17025 & AOAC accreditation
✔ Analytical chemistry and microbiology expertise
✔ Experience in regulated laboratory environments
✔ Practical, implementation-focused consulting
Industries We Serve
✔ Dietary Supplement/Nutraceuticals
✔ Food & Beverage
✔ Pharmaceuticals
✔ Environmental
✔ Chemical Testing
Free Resource for Laboratories
ISO/IEC 17025 Accreditation Readiness Checklist
Identify gaps in your laboratory quality system before your accreditation assessment.
Complete the form below to download the checklist instantly.
Our Services
We offer structured consulting packages to help laboratories strengthen their quality systems and achieve accreditation efficiently.
-
Identify gaps before the auditors do.
This service is ideal for laboratories that want to understand how close they are to meeting accreditation requirements.
We conduct a structured review of your laboratory’s quality system against ISO/IEC 17025 and AOAC accreditation requirements.
Deliverables
Quality system gap assessment
Documentation review
Identification of compliance risks
Detailed findings report
Prioritized action plan for accreditation readiness
Typical outcomes
Laboratories gain a clear understanding of:
What is already compliant
What needs improvement
What steps are required to achieve accreditation
-
Build a complete and functional laboratory quality management system.
For laboratories that need to establish or significantly strengthen their quality systems, we design and implement a structured Quality Management System (QMS) aligned with accreditation standards.
Services may include
Quality manual development
SOP and documentation creation
Document control system implementation
CAPA system development
Internal audit program design
Training and competency documentation
Data integrity procedures
Compliant handling
Typical outcomes
Laboratories gain a fully operational quality system designed to support accreditation and long-term compliance.
-
End-to-end support for laboratories pursuing accreditation.
This comprehensive service guides laboratories through the complete accreditation journey—from initial assessment to final audit preparation.
Services include
Accreditation readiness assessment
Quality system development or improvement
SOP and documentation development
Internal audit and mock assessment
Corrective action support
Staff training and preparation
Accreditation application guidance
Typical outcomes
Laboratories are fully prepared for accreditation assessments and equipped with sustainable quality systems.
-
Laboratories may also request targeted services such as:
SOP development
Method validation guidance
Internal audits
CAPA investigations
Data integrity assessments
Ongoing quality advisory support
-
Our services can be delivered through:
Project-based consulting
Remote advisory sessions
On-site quality system development
Ongoing quality support engagements
Schedule your appointment
Have questions about accreditation or your laboratory’s quality system? Schedule a consultation to discuss your needs and explore how we can help strengthen your laboratory’s compliance and readiness.
Contact Us
Have questions about laboratory accreditation or your quality management system? We’re here to help.
Whether you need quick guidance, support developing SOPs, or assistance building a fully compliant quality system, Lab Accreditation & Quality Partners provides practical solutions tailored to your laboratory’s needs.
Complete the contact form or reach out directly to discuss how we can support your accreditation and compliance goals.